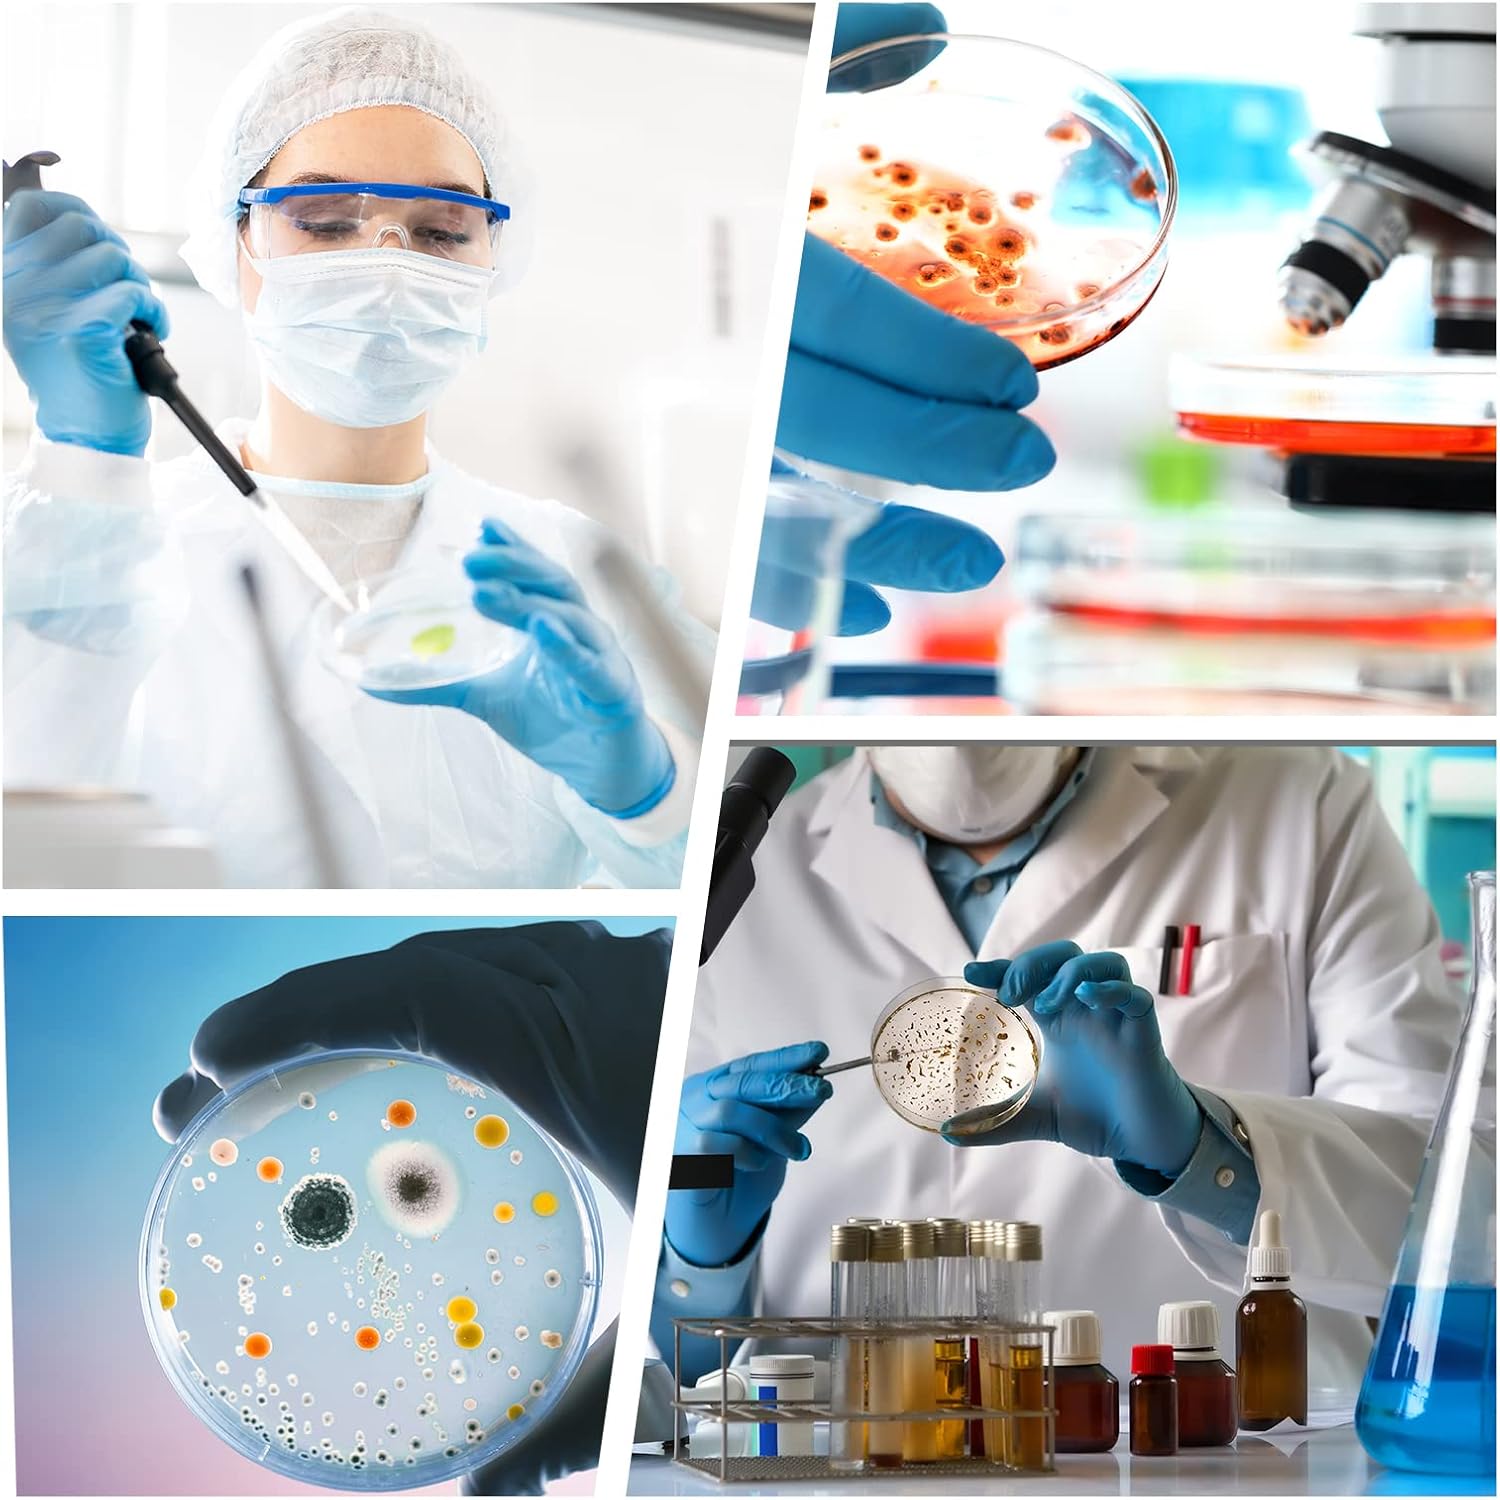
c0186ce3419f099ce7f8f1993b92265a.jpg

We offer a set 100 pieces sterile plastic petri diameter 100 mm, ideal for a wide range of laboratory applications and scientific experiments. These high quality dishes are made of durable and transparent plastic, which allows easy observation of all occurring processes. Each scale is supplied with a tailored lid, which ensures optimal conditions for storing and insulating samples. Thanks to the use of the best materials, our scales are reliable and meet quality standards required in laboratories.

Petri dishes from Vabiooth are not only durable, but also extremely functional. They have been designed for easy use, which makes them ideal for professionals and students during science. Ideally suited for bacterial breeding and other microorganisms, as well as for various biological and chemical experiments. The correct use of these laboratory vessels is crucial to obtain accurate test results and sampling integration. Therefore, each element of the set is carefully made to meet the expectations of even the most demanding users.

One of the key assets of our product is sterility, which guarantees that there is no risk of contamination of samples. A set of sailors is specially packed to ensure maximum freshness and safety. In addition, their project enables effective ventilation thanks to three-mentioned holes, which is important in many biological processes. Thanks to this, the user is sure that all processes occur under appropriate conditions, which affects the success of the experiments carried out.
- Material: Transparent high quality plastic
- Dimensions: 100 mm in diameter, 15 mm depth
- Packaging: A set of 100 pieces with lids
- Sterile: Ready to use, provide no contamination
- Ventilation: Three ventilation openings for optimal culture conditions
- Versatility: Perfect for use in laboratories, schools and scientists
By choosing our Petri dishes, you invest in the quality that supports your research and experiments. Each scale is carefully tested to ensure its appropriate properties and functionality. Convince yourself how many possibilities give you our product - from driving microorganisms to various laboratory tests. Trust your experience and choose scales that stand out from other available on the market. Our offer is a great solution for all who are looking for proven tools to work in the laboratory.

 Secure payment
Secure payment
 Easy going back
Easy going back
 Fast delivery
Fast delivery